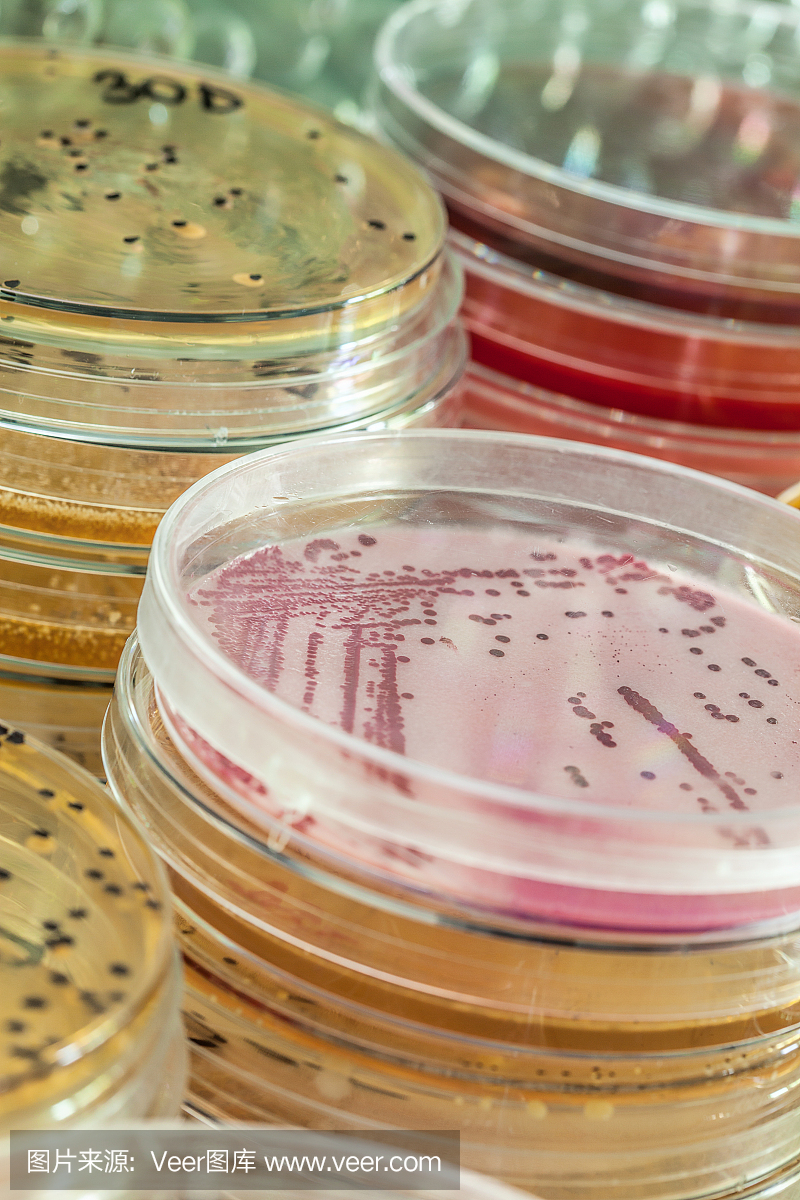
细菌检测

HiDtect快速鉴定纸是细菌学检测的一场革命! - 企业动态 - 丁香通
640x664 - 19KB - JPEG

实验检测手机表面细菌脏过马桶18倍
400x271 - 54KB - JPEG

如何检测感染细菌数目_细菌检测_细菌感染_医脉通
900x642 - 72KB - JPEG

DNA作微观机器引擎 可检测病毒细菌乃至金属_DNA 检测_行业动态_中国化工仪器网
400x250 - 43KB - JPEG

手持式ATP荧光检测仪(进口)\/细菌检测仪 型号
400x531 - 25KB - JPEG

奶粉检测无大碍 超级细菌不可怕 --洛阳晚报-
300x273 - 27KB - JPEG

医疗细菌病毒检测
750x500 - 96KB - JPEG
细菌检测
800x1200 - 966KB - JPEG

ATP-ATP荧光检测仪 ,细菌检测仪, 洁净度检测
437x577 - 24KB - JPEG

发明快速检测细菌抗药性微型装置_细菌检测_
584x438 - 378KB - PNG

手机比快递脏10倍 常用物细菌知多少
900x599 - 517KB - JPEG

革兰氏染色剂,细菌检测,革兰氏染色法测试,细菌
1200x900 - 804KB - JPEG

革兰氏染色剂,革兰氏染色阴性,细菌检测,革兰氏
1200x800 - 1263KB - JPEG

高品质灭菌医用培养皿用于培养细菌检测图片,
684x432 - 16KB - JPEG

PJ-ATP ATP荧光检测仪\/细菌检测仪_食品检测
400x400 - 35KB - JPEG
科标化工分析检测中心是专业的第三方分析检测机构,提供细菌检测,10种常用细菌检测方法在此分享。 专业文档 专业文档是百度文库认证用户/机构上传的专业性文档,文库VIP
但实际上这个认知并不正确。通常情况下,女性过了十八岁以后,就需要定期做检查,即便身体没有什么问题,也没有结婚,或者是没有男朋友,也是需要
(4)产超广谱β-内酰胺酶的肠杆菌科细菌检测:超广谱β-内酰胺酶是一种能水解青霉素、广谱头孢菌素及单胺类的酶,主要由克雷伯菌、肠杆菌等细菌
细菌鉴定及检测方法 马背女孩上传于2011-01-09|暂无评价|0|0|简介|举报 检测方法 阅读已结束,下载文档到电脑 0下载券 下载 想免费下载更多文档?立即加入VIP 免下载券下载
磷酸盐缓冲液对食品中已受损伤的细菌细胞有一定的保护作用 是的,所以说并不抵触,因 现行有效的食品微生物学系列检测国家标准,是“推荐性”标准,不是强制性的。我理解
看结果是正常的。tct检查主要是看宫颈有没有病变,现在看没有。 强身健体,养成良好的生活、工作习惯,戒烟、戒酒,忌熬夜,合理饮食,放松心情,避免经常接触有毒、有害物质,洁身自爱,避免感染性传播疾病和反复流产,选择合适的生育时机。
细菌抗体检测是指用已知细菌或细菌抗原检测体液中有无相应抗体及抗体效价的动态观察方法,用于感染性疾病的辅助诊断,特别适用于不能人工培养或难以培养的病原体引起的
共有细菌基本知识和检测方法资料 1609条 地址:青岛市高新区锦汇路1号A2栋 电话:400-0532-596 0532-66087773 66087762、81935169 传真:0532-81935080 66087775 邮
求细菌检测方法? 作者研究生6969 我在做真菌发酵实验,以后准备产业化,但是经常会被细菌感染,从而造成损失,请问有什么方法或仪器可以快速检测细菌感染?返回小木
你好顾名思义就是检查有没有细菌感染,一般检查的话就是,普通的细菌检查,不会分得那么细致。 2016-12-09 23:01 投诉 武义超 主治医师 安平县人民医院 擅长:脑血管疾病如脑